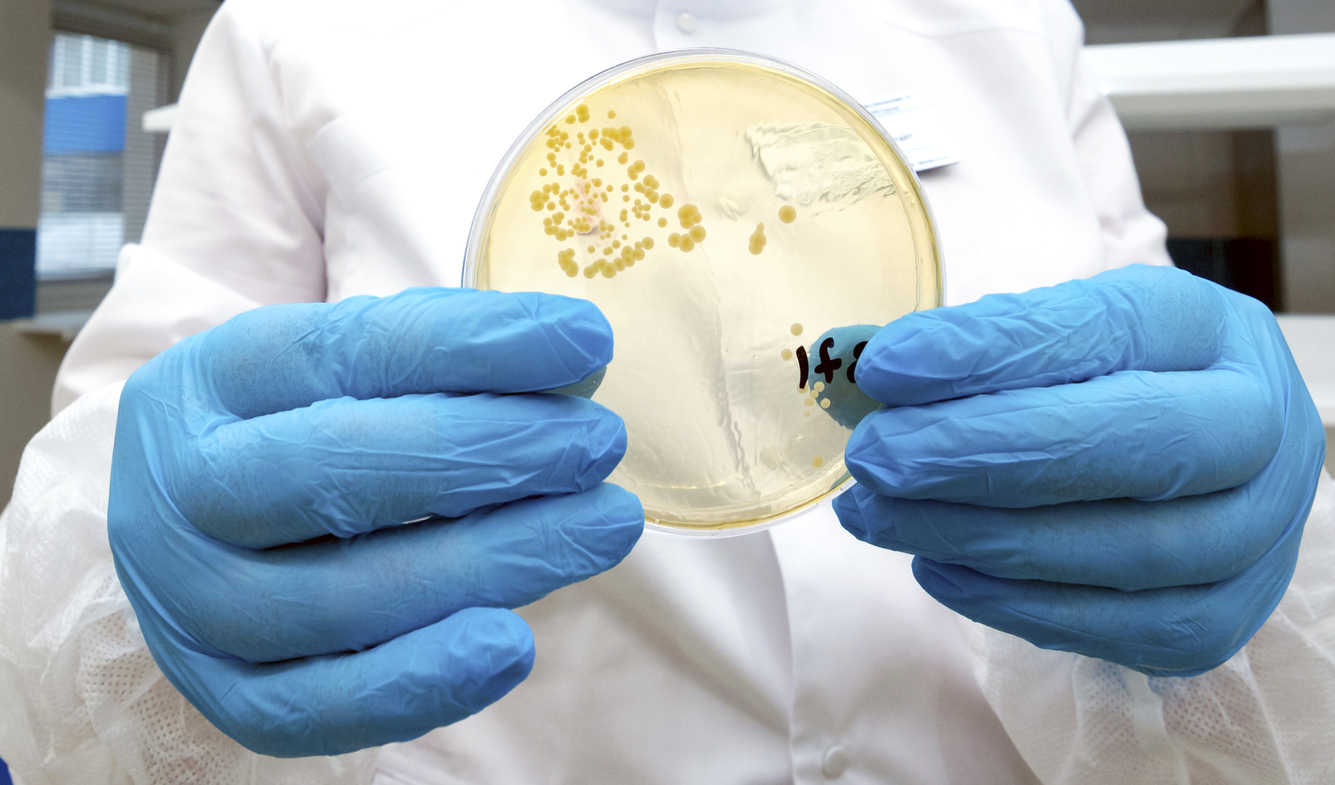

Διεισδυτικός στρεπτόκοκκος: 5 πληροφορίες που οι παιδίατροι και ο ΕΟΔΥ θέλουν να ξέρετε
Αν και το Ευρωπαϊκό Κέντρο Ελέγχου και Πρόληψης Νοσημάτων (ECDC) εκτιμά πως δεν υπάρχει μεγάλη αύξηση των περιστατικών και χαρακτηρίζει “μικρό” τον κίνδυνο από διεισδυτικό στρεπτόκοκκο iGAS, τα 94 κρούσματα και οι 23 θάνατοι σε παιδιά και ενήλικες που έχουν εντοπιστεί στη χώρα μας, έχουν θέσει σε συναγερμό τις αρμόδιες υγειονομικές αρχές.
Τελευταία κρούσματα της διεισδυτικής νόσου iGAS ήταν δύο, το ένα εκ των οποίων κατέληξε στην ΠΕ Ανατολικής Μακεδονίας Θράκης.
Το 9χρονο κοριτσάκι από το Διδυμότειχο μάλιστα, χάθηκε την περασμένη Δευτέρα (05.02.24) μέσα σε μόλις 2,5 ώρες από τη στιγμή της διακομιδής του στο νοσοκομείο από τη μητέρα του.
Η αγωνία των αρχών αλλά και των γονιών κορυφώνεται αυτήν την περίοδο, καθώς η συχνότητα εμφάνισης της φαρυγγίτιδας από GAS αυξάνεται κατά τους χειμερινούς μήνες και τις αρχές της άνοιξης, ενώ συχνά αναφέρονται συρροές κρουσμάτων σε νηπιαγωγεία και σχολεία, όπως ανέφερε στην ανακοίνωσή του ο ΕΟΔΥ.
Να σημειωθεί πως ο Οργανισμός έχει ζητήσει από όλες τις δομές υγείας να δηλώνουν άμεσα όλα τα περιστατικά iGAS που εντοπίζονται στη χώρα.
Το iatropedia.gr απευθύνθηκε στην πρόεδρο της Ένωσης Ελευθεροεπαγγελματιών Παιδιάτρων Λάρισας, Γεωργία Νταμάγκα, η οποία επισημαίνει 5 σημαντικά σημεία στην έκθεση του ΕΟΔΥ, στα οποία θα πρέπει να εστιάσουν οι γονείς και οι πολίτες της χώρας, αναφορικά με τον διεισδυτικό στρεπτόκοκκο.
1) Από στρεπτόκοκκο iGAS κινδυνεύουν και οι ενήλικες
Σύμφωνα με τον ΕΟΔΥ, εντός του 2023 και μέχρι σήμερα έχουν δηλωθεί 23 θάνατοι, εκ των οποίων οι 12 ήταν σε ενήλικες και οι 11 σε παιδιά κάτω των δέκα ετών.
Οι αριθμοί αποδεικνύουν πως οι ενήλικες κινδυνεύουν εξίσου αν όχι και περισσότερο από τα παιδιά.
“Ιδιαίτερα προσεκτικοί θα πρέπει να είναι οι ενήλικες όταν στο περιβάλλον τους διαβιούν παιδιά με στρεπτοκοκκικές αλλοιώσεις, καθόσον η μεταδοτικότητα και διασπορά του μικροβίου είναι μεγάλη”, αναφέρουν οι Παιδίατροι της Λάρισας σε ανακοίνωσή τους, ενώ η πρόεδρος τους, κα. Νταμάγκα, προσθέτει:
“Είναι σημαντικό να τονιστεί πως το πρόβλημα αυτό αφορά και τους ενήλικες, που διαβιούν στο περιβάλλον ενός παιδιού το οποίο νοσεί. Δεν είναι αμελητέο ότι μπορεί να νοσήσουν και οι ενήλικες και αντίστοιχα είδατε ότι είχαμε και τον 28χρονο εδώ από την περιοχή μας από τον Τύρναβο που κατέληξε σε νοσοκομείο. Δεν είναι κι αυτό αμελητέο”, αναφέρει η ειδικός και προσθέτει δεδομένα από την κλινική της εμπειρία:
“Βλέπουμε πολύ συχνά σε περιπτώσεις που νοσεί το παιδί να νοσεί και η υπόλοιπη οικογένεια”, τονίζει.
2) Προσοχή στη μετάδοση από ανοιχτές πληγές και σταγονίδια
Ο στρεπτόκοκκος τύπου Α μεταδίδεται από άτομο σε άτομο αερογενώς με τα σταγονίδια και με την επαφή με δερματικές αλλοιώσεις, αναφέρει ο ΕΟΔΥ, ενώ οι Παιδίατροι εξειδικεύουν περαιτέρω:
“Το συγκεκριμένο μικρόβιο μπορεί να προκαλέσει σε ορισμένες περιπτώσεις λοίμωξη, ήπια (αμυγδαλίτιδα, φαρυγγίτιδα, οστρακιά, μολυσματικό κηρίο) ή και πιο σοβαρή μετά από διείσδυση (πνευμονία, εμπύημα, νεφρίτιδα, καρδίτιδα, ρευματικό πυρετό, σηψαιμία), κυρίως όταν ένα άτομο έχει ανοιχτά τραύματα που επιτρέπουν στα βακτήρια να εισέλθουν στους ιστούς, βλάβες στην αναπνευστική οδό μετά από ιογενές νόσημα ή σε περιπτώσεις μειωμένης ανοσίας σε κάποια λοίμωξη, λόγω υποκείμενων νοσημάτων ή φαρμακευτικής αγωγής”.
Επίσης, τα συμπτωματικά άτομα μεταδίδουν περισσότερο από τους φορείς.
Πώς μπορεί κάποιος να προφυλαχθεί:
“Με τα γνωστά μέτρα υγιεινής που ισχύουν για όλες τις λοιμώξεις. Καλό πλύσιμο χεριών, καλή υγιεινή, να μην χρησιμοποιούμε κοινά σκεύη. Ο στρεπτόκοκκος μεταδίδεται με τα σταγονίδια της αναπνοής, μερικές φορές μπορεί να συμβεί επιμόλυνση και μέσω ανοιχτών πληγών οπότε έχουμε τη μετάδοση του στρεπτοκόκκου και με αυτές τις δύο οδούς”, αναφέρει η κα. Νταμάγκα στο iatropedia.gr.
3) Πολλά ψευδή αποτελέσματα όταν τα strep test δεν γίνονται από ειδικό
Σύμφωνα με ανακοίνωση των Ελευθεροεπαγγελματιών Παιδιάτρων Λάρισας, τα κύρια συμπτώματα του στρεπτόκοκκου τύπου Α είναι ο πυρετός (όχι κατ’ ανάγκη υψηλός), που συνοδεύεται συνήθως από ρίγος, ο πονόλαιμος και σε αρκετές περιπτώσεις από διόγκωση των τραχηλικών λεμφαδένων και των αμυγδαλών.
“Η διάγνωση επιβεβαιώνεται στο εργαστήριο είτε με γρήγορο τεστ (strep test), είτε με καλλιέργεια από τον φάρυγγα, απ’ όπου ο ασθενής λαμβάνει το αποτέλεσμα εγγράφως με την υπογραφή και την σφραγίδα του γιατρού. Ιδιαίτερη προσοχή χρειάζεται στα strep test αυτοδιάγνωσης που διενεργούνται εκτός εργαστηρίου ή ιατρείου, καθόσον η λήψη του υλικού από το ρινοφάρυγγα απαιτεί ιδιαίτερη γνώση και δεξιότητα”, αναφέρουν.
Το ίδιο επισημαίνει και ο ΕΟΔΥ, στην χθεσινή του ανακοίνωση:
Η καλλιέργεια φαρυγγικού επιχρίσματος “συστήνεται να λαμβάνεται από επαγγελματία υγείας”, αναφέρεται συγκεκριμένα.
Η παιδίατρος κ. Νταμάγκα αποκαλύπτει πως τόσο η ίδια όσο και οι συνάδελφοί της έχουν έρθει αντιμέτωποι πολλές φορές με ψευδείς διαγνώσεις.
“Έχουμε πολλά ψευδή αποτελέσματα όταν τα τεστ τα κάνουν γονείς ή άνθρωποι που δεν είναι επαγγελματίες Υγείας. Μου έχουν τύχει τέτοια περιστατικά και σε μένα και στους συναδέλφους μου. Υπάρχουν πάρα πολλά λάθη όταν το τεστ το κάνει κάποιος που δεν είναι ούτε μικροβιολόγος, ούτε παιδίατρος, ή όταν η διάγνωση δεν γίνεται σε νοσοκομείο από εξειδικευμένο προσωπικό. Σίγουρα δεν μπορεί να κάνει strep test o γονιός που δεν έχει εκπαιδευτεί κατάλληλα. Δεν είναι self test το strep test”, σημειώνει η γιατρός.
4) Την αντιβίωση τη χορηγεί αποκλειστικά ο γιατρός
Σύμφωνα με τις συμβουλές των Παιδιάτρων, η θεραπεία στις ήπιες λοιμώξεις γίνεται στο σπίτι, είναι απλή, με κοινά αντιβιοτικά (πενικιλίνη ή ερυθρομυκίνη ή κεφαλοσπορίνη), ενώ οι βαριές λοιμώξεις από τον διεισδυτικό στρεπτόκοκκο απαιτούν νοσηλεία σε νοσοκομεία.
Ωστόσο, σύμφωνα με την πρόεδρο των Παιδιάτρων, η χορήγηση της αγωγής πρέπει πάντα να γίνεται πάντα από ειδικό.
“Δεν πρέπει να δίνουμε αγωγή σε ένα παιδί, μόνο και μόνο επειδή μπορεί να παρουσιάζει κάποια συμπτωματολογία που προσομοιάζει με τον στρεπτόκοκκο. Πάντοτε θα πρέπει να παίρνει αγωγή μετά την κατάλληλη εξέταση από τον γιατρό, γιατί καμιά φορά ένα τεστ από μόνο του δεν αρκεί. Το παιδί με στρεπτόκοκκο μπορεί να έχει κι άλλα συνοδά ευρήματα και μετά να περάσει στη διεισδυτική λοίμωξη, γι’ αυτό χρειάζεται η εκτίμηση από θεράποντα γιατρό. Η αντιμικροβιακή αγωγή δεν χορηγείται μόνο επειδή έχουμε ένα θετικό τεστ και επειδή έχει “ξεμείνει” στο σπίτι μας μια αντιβίωση από παλιά”.
Τέλος, ο ΕΟΔΥ υπογραμμίζει πως θα πρέπει να εντοπίζονται οι στενές επαφές των περιπτώσεων iGAS στο οικιακό και σχολικό περιβάλλον, να εκτιμάται η κατάστασή τους και να αντιμετωπίζονται σύμφωνα με τις κατευθυντήριες οδηγίες με χορήγηση προφυλακτικής αντιμικροβιακής αγωγής όπου ενδείκνυται.
“Η χημειοπροφύλαξη, η αντιβίωση δηλαδή, θα πρέπει να τη λαμβάνει και το περιβάλλον μόνο εάν το συστήσει ο ειδικός και κατόπιν εκτίμησης της καταστάσεων”, εξηγεί περαιτέρω η Παιδίατρος.
5) Ο στρεπτόκοκκος iGAS εμφανίζεται μετά από άλλη ίωση
“Τα παιδιά με ιογενείς λοιμώξεις όπως η γρίπη, διατρέχουν υψηλότερο κίνδυνο να αναπτύξουν λοίμωξη από iGAS”, αναφέρει ο ΕΟΔΥ.
Η ειδικός εξηγεί:
“Όταν ένα παιδί έχει νοσήσει από ένα ιογενές νόσημα και φέτος είχαμε πάρα πολλά ιογενή νοσήματα και κοξάκι και γρίπη και COVID-19 σίγουρα έχει εξασθενήσει το ανοσοποιητικό του. Ένα παιδί που είναι πιο ευάλωτο, πιο καταβεβλημένο είναι πολύ πιο επίνοσο. Αυτό ισχύει για όλες τις ιώσεις. Το αναφέρει ο ΕΟΔΥ γιατί είχαμε πάρα πολλά κρούσματα γρίπης. Το κατ’ εξοχήν πρόβλημα στα παιδιατρικά ιατρεία σε όλο το διάστημα με τις γιορτές και μετά τις γιορτές ήταν η γρίπη”, αναφέρει.
Σύμφωνα με την κα. Νταμάγκα αμέσως μετά την ανάρρωση από μια ιογενή λοίμωξη -είτε ο ενήλικας, είτε το παιδί– θα πρέπει να λαμβάνονται κάποια μέτρα προφύλαξης τουλάχιστον μέχρι την πλήρη ανάρρωση.
“Ένα παιδί θα πρέπει να επιστρέφει στα καθήκοντά του και τις δραστηριότητές του κανονικά μετά την πλήρη ανάρρωση, όπως αντίστοιχα και ο ενήλικας να κάνει το ίδιο. Και βέβαια αφού επιστρέφει μετά να είναι σε καλή κατάσταση και να μην βιάζεται να επιστρέψει σε δραστηριότητες που μπορεί να είναι κοπιαστικές και μπορεί να εξασθενήσουν τον οργανισμό του. Να έχει κανείς μια καλή – καλή ανάρρωση. Το διάστημα που θα απαιτηθεί εξατομικεύεται ανάλογα με τον οργανισμό και με τη σφοδρότητα της ίωσης που πέρασε. Όταν νιώσει καλύτερα”, αναφέρει η γιατρός.
Πολύ σημαντικό!
Η Ένωση Ελευθεροεπαγγελματιών Παιδιάτρων Λάρισας επισημαίνει, επίσης, τα εξής:
Επειδή στα παιδιά και ιδιαίτερα τα μικρότερα, οι μικροβιακές λοιμώξεις εξαπλώνονται πολύ γρήγορα και καταλήγουν σε σηψαιμία (όταν περάσει στο αίμα και προκαλείται σηπτικό shock), οι γονείς θα πρέπει όταν βλέπουν πυρετό που συνοδεύεται από ρίγος, πρησμένες αμυγδαλές με πύον, εξάνθημα με κηλίδες και το παιδί χάνει την ζωηράδα του (κάθεται «μαραμένο», δεν παίζει με τα παιχνίδια, δεν μιλάει πολύ) να επικοινωνούν αμέσως ακόμα και από το πρώτο 24ωρο με τον παιδίατρό τους, καθώς όλοι οι παιδίατροι έχουν ευαισθητοποιηθεί και έχουν ενημερωθεί από τους υπεύθυνους υγειονομικούς φορείς.
Θα πρέπει όλοι να συνειδητοποιήσουν πως η έγκαιρη διάγνωση και η γρήγορη αντιμετώπιση με τα κοινά αντιβιοτικά αποτρέπουν περαιτέρω επιδείνωση της λοίμωξης, τις βαριές επιπλοκές και τον θάνατο.